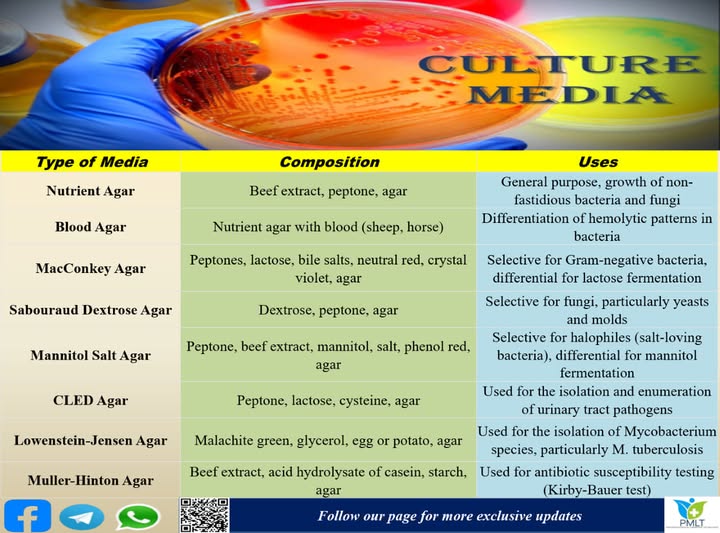
Media Chemicals - Grade: Industrial

Epe Foam Roll - Characteristics: Light In Weight
Price: 2832.00 INR / Unit
(2400.00 INR + 18% GST)
Get Latest Price
MRP:
2832.00 INR / Unit
Weight :
7.00 Kilogram
1 Pack Contains :
1
Minimum Pack Size :
1
In Stock
Product Specifications
| Color | WHITE/BLACK |
| Texture Type | CUSTMIZED |
| Usage & Applications | INDUSTRIAL PARTS PACKING / FURNITURE MAUFACTURERS/ EXPORTERS |
| Print Type | NO |
| Material | FOAM TYPE |
| Weave Style | NO |
| Width | AS PER REQUIREMENT Meter (m) |
| Length | 200 Meter (m) |
| Application | PACKAGING OF INDUSTRIAL/TEXTILE/PHARMA/FURNITURE PACKING |
| Fabric Type | LLDPE FOAM |
| Type | Stretch Film |
| Texture | Sponge |
| Product Style | Plain |
| Thickness | AS PER REQUIREMENT Millimeter (mm) |
| Shape | Rectangle |
| Hardness | Rigid |
| Packaging | Rolls |
| Disposable | No |
| Size | AS PER REQUIRNMENT |
| Pattern | Plain |
| FOB Port | INDIA |
| Payment Terms | Paypal, Cash Against Delivery (CAD), Cash on Delivery (COD), Cash Advance (CA), Cash in Advance (CID), Delivery Point (DP), Others, Telegraphic Transfer (T/T) |
| Supply Ability | 200 Per Month |
| Delivery Time | 2 Days |
| Sample Available | No |
| Sample Policy | Free samples are available |
| Packaging Details | ROLL AS PER THICKNESS2MM TO 12 MM ROLL AVAILABLE1.5 MTR HIGHTLENTH - 40 MTR TO 200 MTR AS PER THICKNESS |
| Main Export Market(s) | Asia |
| Main Domestic Market | Gujarat |
| Color | WHITE/BLACK |
| MRP | 2832.00 INR |
| Packsize | 1 |
| Returnable | No |
| Pkg Box Length | 4000.00 cm |
| Price Type | fixed |
| Currency | INR |
| Brand Name | NA |
| Pkg Box Height | 140.00 cm |
| Unit Type | Unit/Units |
| Stock Quantity | 100 |
| Weight | 7.00 Kilogram |
| GSTIN | 18% |
| Mop | 1 |
| Price | 2400.00 INR (Approx.) |
| Pkg Box Breadth | 1.00 cm |
| Shipping Type | free |
| Minimum Ordered Packs | 1 |
Product Overview
Key Features
SHEET SIZE-15MM TO 100MM
Company Details
Business Type
Manufacturer, Distributor, Supplier, Trading Company
Employee Count
6
Establishment
2023
Working Days
Monday To Sunday
GST NO
24ABYFM3189K1ZF
Payment Mode
Cheque/DD, Wallet & UPI, Online Payments (NEFT/RTGS/IMPS)
Related Products
Explore Related Categories
More Products From This Seller
Seller Details
GST - 24ABYFM3189K1ZF
Ahmedabad, Gujarat
Proprietor
Mr Parth Panchal
Members since
2 Years
Address
22, Center One Arcade, Near Royal Ind Park, Ahmedabad, Gujarat, 382430, India
epe foam roll in Ahmedabad
Report incorrect details